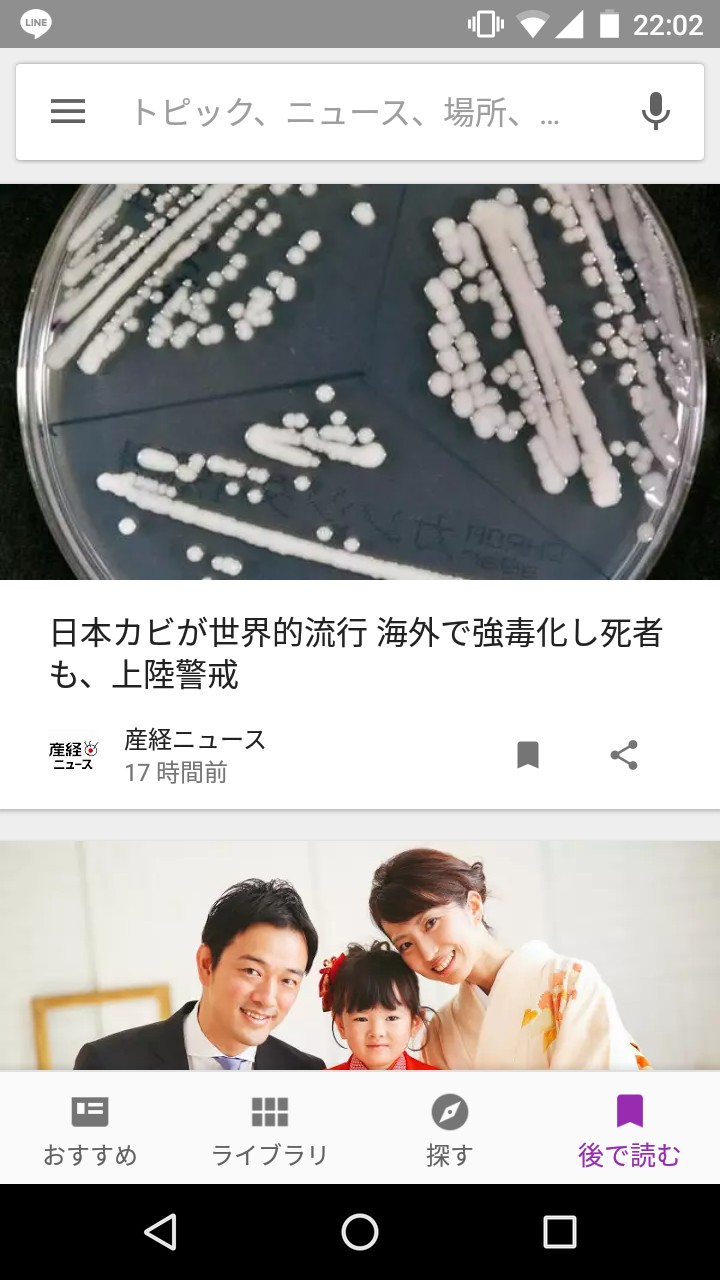

- アプリの選び方
- おすすめアプリの紹介
- まとめ
目次
世の中には毎日、たくさんのニュースが流れています。住んでいる地域のことや、スポーツ、日本の政治、事件、各国の世界情勢など、知っておきたいニュースは日々変わります。皆さんは毎日、どのようにして気になるニュース記事をチェックしていますか?最近ではネット上でニュースを読んでいると人も多いと思いますが、すぐには読めないこともあるのではないでしょうか。そんな時におすすめするのが、後で読むサービスがあるアプリです。記事を保存しておき、後でゆっくり読める、便利で使い勝手の良いニュースアプリを見つけて使ってみましょう。
アプリの選び方
さまざまなアプリから、便利で使いやすいニュースアプリをどのようにして選ぶと良いでしょうか。選び方のポイントを紹介します。
自分の興味のあるニュースが充実しているか
まず大切なのは、ニュースアプリが自分の興味のある記事や情報をチェックできるかどうか、ということです。スポーツに関心がある人は、スポニチや日刊スポーツなどの、新聞記事が見られるかどうかも、ポイントのひとつになるでしょう。また、地域のニュースや芸能ニュースをおもに読みたい人、世界情勢をリアルタイムでチェックしたい人など、自分に合ったアプリをダウンロードすることで、必要な情報をいち早く知ることが可能になります。
ジャンルが分かれていて、読みやすいアプリになっているか
多くの情報を毎日チェックする中で、画面の見やすさもポイントのひとつです。ジャンル分けがされることで、興味のあるメディアやトピックを素早くチェックできます。気になるフリーワードを登録しておくことで、自分が関心のある時事を読める機能の付いたアプリは、忙しい朝などにも便利です。
おすすめアプリの紹介
Google Play ニューススタンド
画像:著者撮影
「Google Play ニューススタンド」では、日本のおもな新聞や雑誌なども充実しているため、幅広い分野から情報を得ることができます。時間をかけずに見出しをチェックすることができるように工夫されており、関心のあるトピックについての特集記事や動画なども探すことも可能。フィードバック送信オプションがあるため使うたびに精度がアップし、自分に合った使い方が可能になる便利なアプリです。ニュースや雑誌などをダウンロードしてオフラインで読むことができるので、後で読む機能と合わせて、便利に使うことができます。外出先などでちょっとした隙間時間を有効に使いたい人におすすめのアプリです。
電子新聞
画像:著者撮影
新聞で最新のニュースや社説、そのほかの記事を読みたいという人におすすめのアプリです。日付検索ボタンで過去3カ月の記事をダウンロードして読むことができます。すぐに読めない記事は、4日分の保存が可能。オフラインで後から読むことができるため、時間のない時や気になる記事の保存などに便利です。画面は新聞の紙面表示と、テキスト表示から、自分の読みやすい方で選択できます。文字の大きさも変えることもでき、分かりやすい画面表示と検索のしやすさも魅力。新聞を手軽に持ち歩く感覚でニュースを読みたい人におすすめのアプリです。
スマートニュース
画像:著者撮影
「スマートニュース」は、世の中で話題のニュースを素早くチェックできる、人気のニュースアプリです。政治や経済、スポーツやエンタメなど、気になる話題をピックアップし、時間をかけずに幅広い情報を知りたい、という人におすすめ。写真を多く使い、レイアウトにもこだわった画面で、見やすく読みやすいのが特徴です。自分のタイミングに合わせてニュースの更新時間を設定することができるため、その時に最新の情報を知ることができます。読み込み時間が早いスマートモードで、気になる情報を保存。後でゆっくり読むことができます。朝の忙しい時間を有効に使って最新のニュースをチェックすることが可能なアプリです。
画像:著者撮影
これまでに紹介したニュースアプリのように、後で読む機能がないニュースアプリも多くあります。そこで、ニュースだけでなく、好きなWEBページやビデオなどを後でゆっくり見たい人におすすめのアプリを紹介しましょう。「Pocket」は、保存した記事などを、スマホやタブレットなどのコンピューター間で自動に同期され、ネット環境がなくても手軽に見ることができるのが特徴です。タグ機能付きで、素早く整理することができます。後で読む機能にプラスし、さまざまな便利な機能があるため、色んなシーンで活躍するアプリ。自分のお気に入りを友達にもおすすめすることもでき、「Pocket」などからも最新の面白い情報も得られます。さまざまな楽しみ方が発見できる「Pocket」は、おすすめのアプリです。
まとめ
毎日、さまざまなニュースが飛び交う現代社会。忙しい生活の中ではすぐに読めないニュースも、後で読む機能がひとつあることで、時間の有効活用ができます。ぜひ、自分に合ったアプリを見つけて使いこなしてみてください。